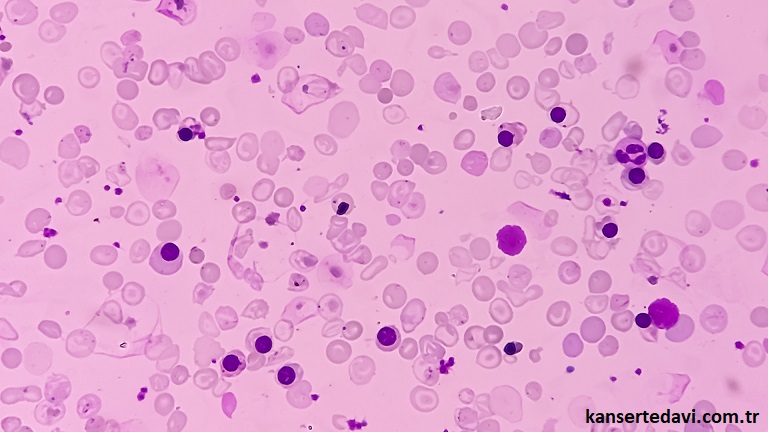
img

Medikal Onkoloji


Medikal Onkoloji
Medikal onkoloji, kanserin ilaçla tedavisini hedefleyen bir tıp dalıdır. Bu alanda uzmanlaşmış doktorlar, kanser teşhisi konulan hastaların tedavi süreçlerini planlayarak, kemoterapi, hormon tedavisi, biyolojik tedavi ve hedefe yönelik tedaviler gibi çeşitli yöntemlerle kanser hücrelerini yok etmeyi veya büyümelerini engellemeyi amaçlar.
Medikal onkologlar, her hastanın kendine özgü genetik ve klinik özelliklerini dikkate alarak kişiselleştirilmiş tedavi planları oluşturur. Hastaların tedavi sürecini izler, yan etkileri yönetir ve tedavinin etkinliğini değerlendirmek için düzenli kontroller yapar. Ayrıca, medikal onkoloji alanında yapılan araştırmalar, kanser tedavisinde yeni ve daha etkili yöntemlerin geliştirilmesine katkıda bulunarak, hastaların yaşam kalitesini artırmayı ve tedavi başarı oranlarını yükseltmeyi amaçlar. Bu multidisipliner yaklaşım, hastaların en iyi bakım ve tedavi seçeneklerine erişmesini sağlar.
Genetik Testler ve Moleküler Profilleme Yöntemleri
Medikal Onkoloji, kanser tanısı ve tedavisi alanında önemli bir alt dal olarak, hastalarda görülen kanser türlerinin moleküler düzeyde incelenmesini ve tedavi stratejilerinin kişiselleştirilmesini sağlar. Bu bağlamda, Moleküler Tümör Profilleme, kanser hücrelerinin genetik yapısını detaylı bir şekilde analiz ederek, tedaviye en uygun yaklaşımın belirlenmesine olanak tanır. HRD Skorlama ise, tümör hücrelerinin DNA tamir mekanizmalarının bozulmasını değerlendirir ve bu bilgi, kanser tedavisinde kullanılan yöntemlerin belirlenmesinde kritik bir rol oynar. Diğer yandan, BRCA1 ve BRCA2 gibi belirli gen mutasyonlarının varlığı, kanser riskini artırabilir. Bu nedenle, BRCA1-BRCA2 Tüm Gen Analizi, hastaların genetik risk profillerini belirlemek ve gerektiğinde önleyici tedbirler almak için önemli bir araçtır. Ayrıca, aile geçmişinde sık görülen kanser türlerini belirlemek ve genetik yatkınlığı değerlendirmek için Herediter (Ailesel) Kanser Paneli kullanılır. Özellikle, kalıtsal meme ve over kanserlerinin belirlenmesi ve erken müdahale için Kalıtsal Meme ve Over Kanser Paneli, risk altındaki bireylerin izlenmesi ve gerekirse tedavi planlarının yapılmasında önemli bir rol oynar. Bu moleküler analiz teknikleri, medikal onkolojide hastaların tedavi süreçlerinin optimize edilmesine ve kanserle mücadelede başarı şanslarının artırılmasına katkıda bulunur.
Medikal Onkoloji Bölümleri
Moleküler Tümör Profilleme
Moleküler tümör profilleme, kanserin genetik ve moleküler özelliklerini belirleyerek kişiye özel tedavi planları oluşturulmasına yardımcı olur. Bu yöntem, kanser tedavisinde daha etkili ve hedeflenmiş bir yaklaşım sunar.
Devamını OkuHRD Skorlama
HRD skorlama, kanser hücrelerinin genetik yapısını inceleyerek, tedaviye duyarlılığı belirler. Bu test, kişiye özel tedavi seçenekleri sunarak kanser tedavisini daha etkili hale getirir.
Devamını OkuBRCA1-BRCA2 Tüm Gen Analizi
BRCA1-BRCA2 tüm gen analizi, meme ve over kanseri gibi kalıtsal kanser risklerini belirlemek için yapılan genetik bir testtir. Bu analiz, kişiye özel tedavi ve önleyici stratejiler geliştirilmesine yardımcı olur.
Devamını OkuHerediter (Ailesel) Kanser Paneli
Kalıtsal kanser, tüm kanserlerin yaklaşık %5-10’unu oluşturur. Kişinin genetik mirası olarak genomunda yer alan tümörden koruyucu genler (tümör baskılayıcı genler), tümöre yatkınlık genleri (onkogenler) ve çevresel etkenler
Devamını OkuKalıtsal Meme ve Over Kanser Paneli
Meme ve over kanserleri, kadınlarda en sık görülen kanser türleri arasında olup, dünya genelinde tüm kanserler içerisinde beşinci sıradadır.
Devamını Oku